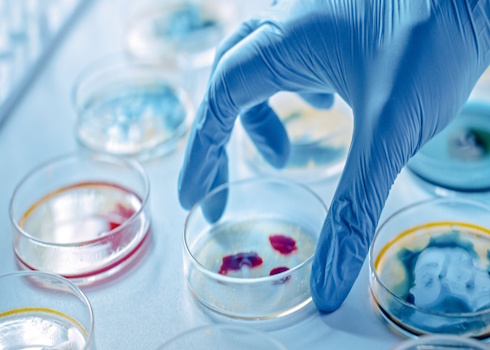

Introduction to Genetic Analysis (12th Ed.) by Griffiths, Doebley, Peichel and Wassarman
The new 12th edition of Introduction to Genetic Analysis takes this cornerstone textbook to the next level. The hallmark focus on genetic analysis, quantitative problem solving, and experimentation continues in this new edition. The 12th edition also introduces Sapling Plus, the best online resource to teach students the problem solving skills they need to succeed [...]